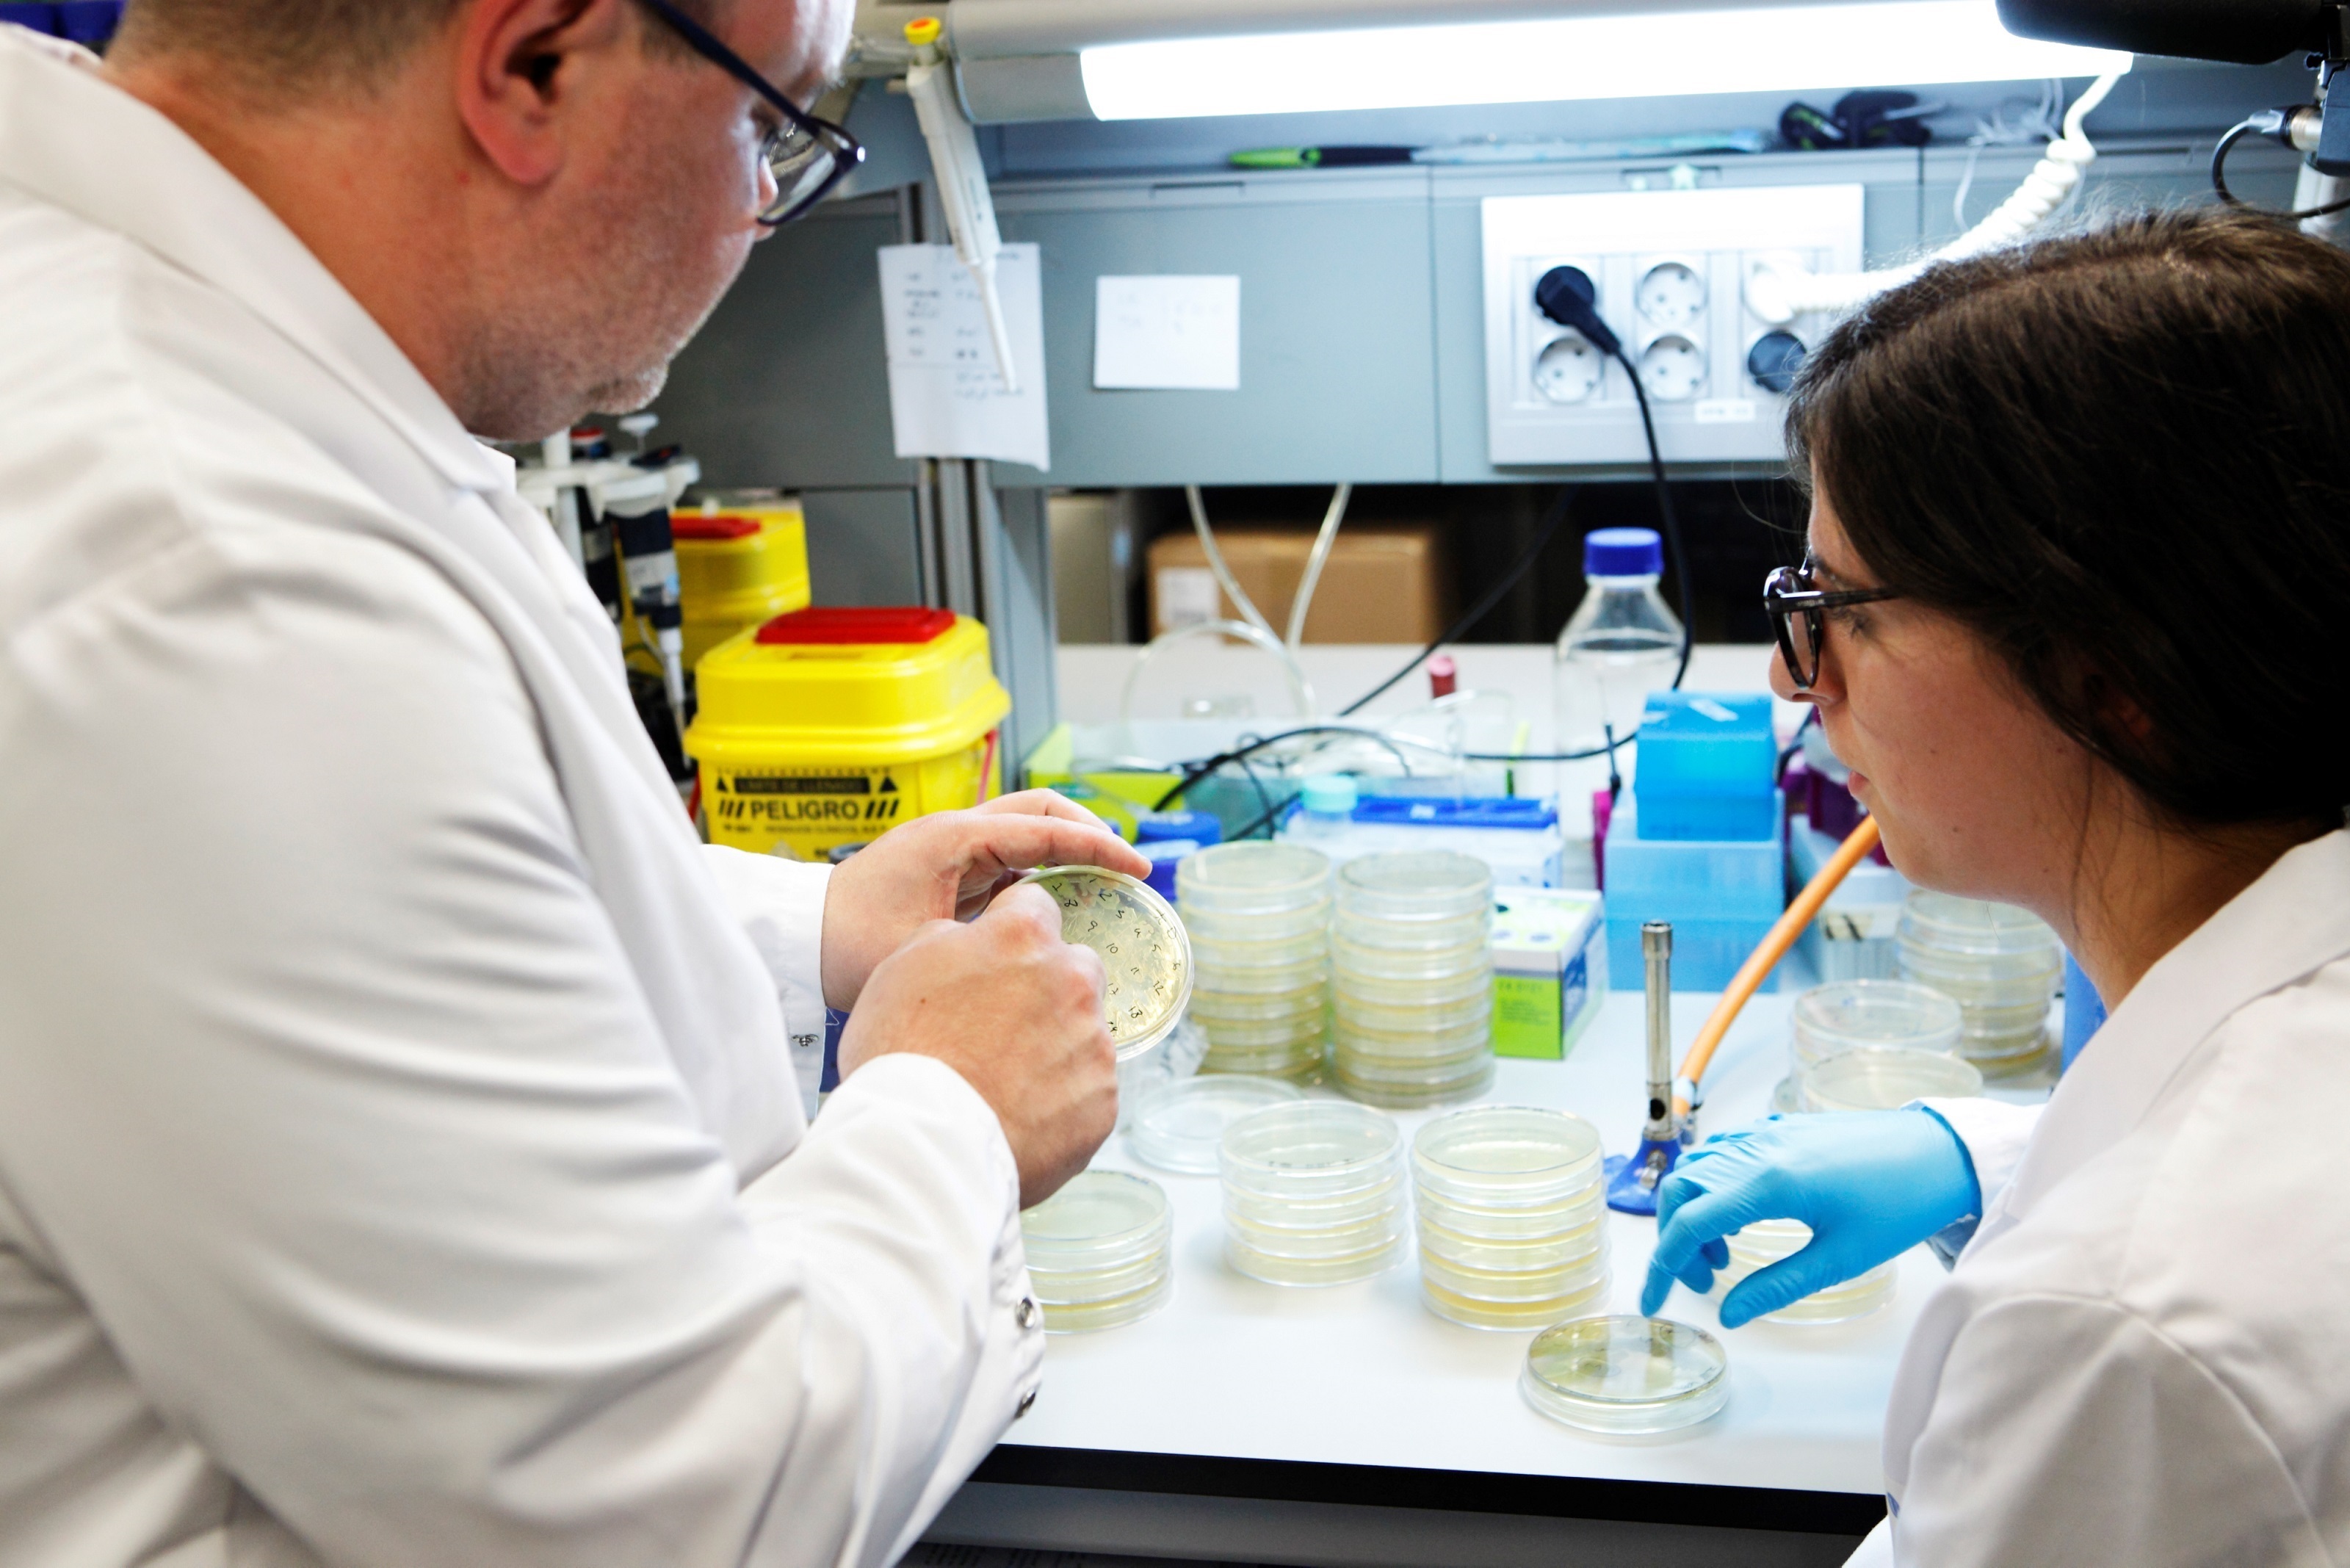

Un fantasma recorre Europa: la secessió
Escòcia i Gal·les recorden, i ens recorden, que la independència no tan sols no és cap aspiració passada i antiga sinó que, per dir-ho en les paraules dels independentistes d’Hong Kong, és el moviment del nostre temps, el fantasma que volta ara mateix per tot Europa